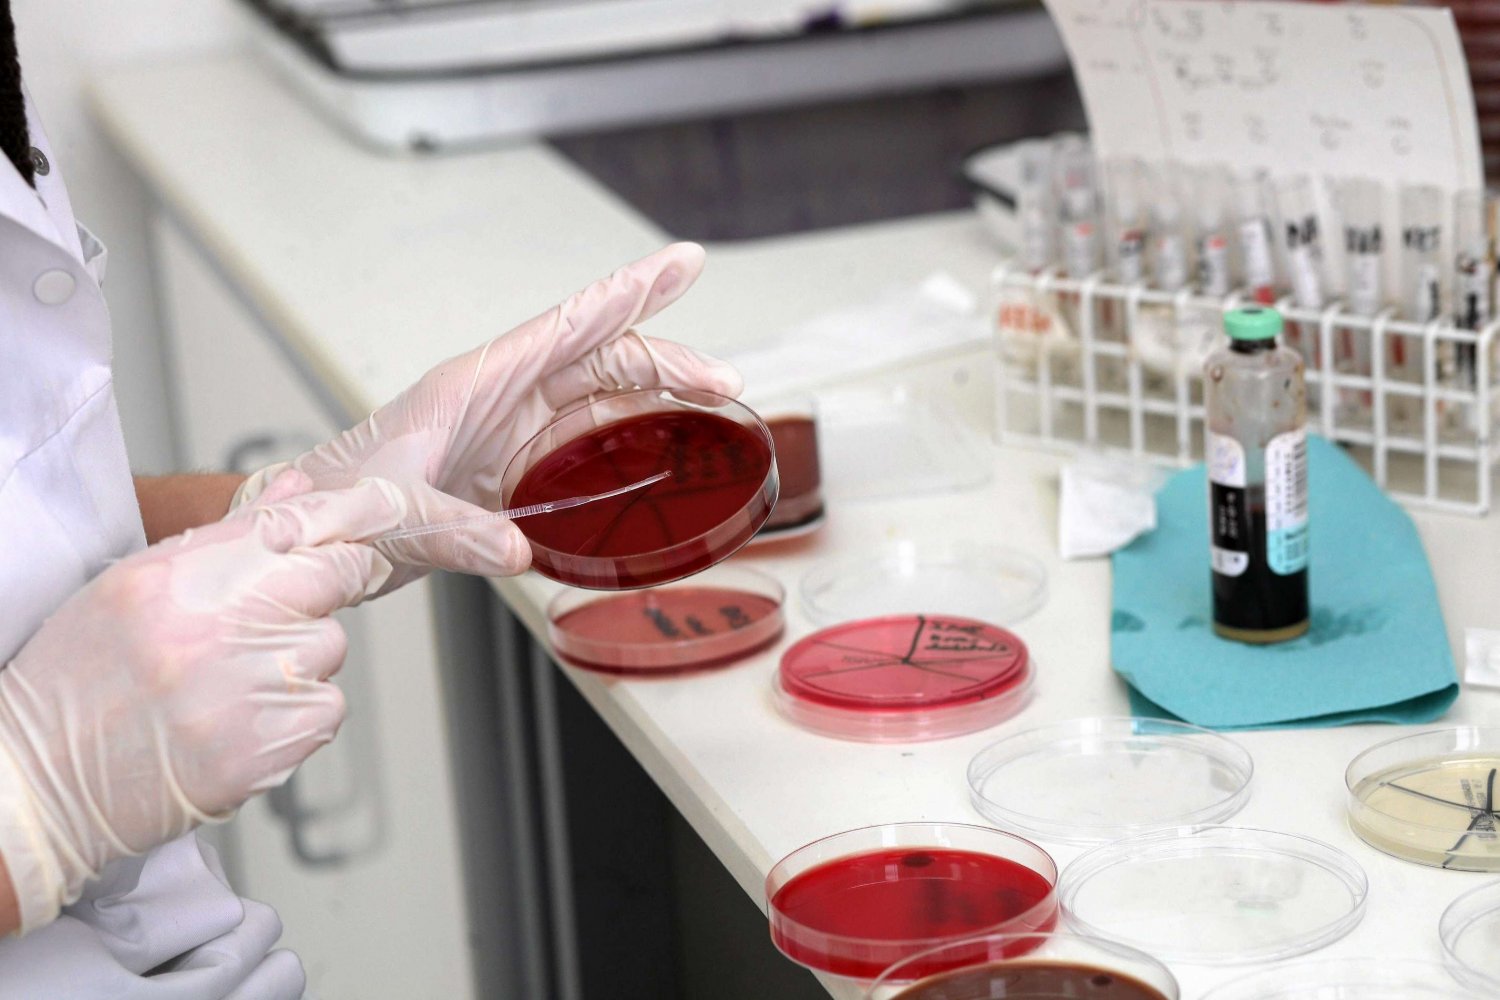
Naukowiec przeprowadza badanie komórek na oddziale mikrobiologii. Białostocki Uniwersytet Medyczny.

Naukowcy z Generalnego Szpitala w Massachusetts przeprowadzili nie lada eksperyment. Z jajników wydzielili komórki macierzyste, które są w stanie generować komórki jajowe. - Do tego typu odkryć podchodzę z rezerwą - mówi nam prof. Marian Szamatowicz.
Metoda bardzo skomplikowana
Bezpłodność to trwała niezdolność do poczęcia dziecka. Może być wywołana operacjami i wypadkami, w wyniku których następuje wycięcie jąder, nasieniowodów czy uszkodzenie jajników, ale też chorobami genetycznymi. Opisywany eksperyment może przyczynić się do znalezienia nowych metod leczenia bezpłodności, ale dopiero za kilka lat.
Niepłodność to zaburzenie, zwykle odwracalne. Mówi się o nim wówczas, gdy para współżyjąca regularnie (2-3 na tydzień) bez antykoncepcji nie może począć dziecka. Istnieją metody leczenia, np. chirurgiczne, hormonalne czy rozrodu wspomaganego.
Bezpłodność to określenie kolokwialne. W języku naukowym mówi się jedynie o niepłodności, względnej - uleczalnej i bezwzględnej - nieuleczalnej. Również w języku angielskim używa się wyłącznie określenia infertility, dosłownie oznaczającego niepłodność.
Nadzieja matką głupich?
